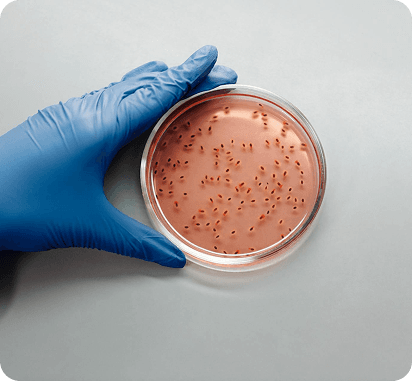
Pathogen Threat Contest

Universe of Threats
Scenario Writing Contests
To date, our four writing contests have brought in over 1,000 entries covering pathogen threats, infrastructure failures, natural disasters and AI threats! Our goal was to attract some of the brightest, most creative minds to the challenge of envisioning a wide range of complex, catastrophic threats that are plausible but entirely unprecedented. We received entries from all over the world, and were extremely impressed by the creativity and writing quality. Thank you to everyone who submitted to the contests. Information about future contests will be posted on our website.

Essay Contests
CAPTRS is building a simulation gaming catalog – CAPTRS Universe of Threats – to address our collective failure of imagination in preparing for future threats. These scenarios will be used to create varied and diverse simulation games to prepare for potential future threats.
The CAPTRS Universe of Threats catalog is being built using a collaboration of human storytelling and artificial intelligence. CAPTRS has completed four threat scenario writing contests, engaging creative writers worldwide in creating plausible threat scenarios for pathogen threats, infrastructure threats, natural disasters and AI threats. All winning essays have been published on the CAPTRS website under the corresponding headings.
The CAPTRS Universe of Threats catalog is being built using a collaboration of human storytelling and artificial intelligence. CAPTRS has completed four threat scenario writing contests, engaging creative writers worldwide in creating plausible threat scenarios for pathogen threats, infrastructure threats, natural disasters and AI threats. All winning essays have been published on the CAPTRS website under the corresponding headings.

AI Threat Contest
September 4 - November 23, 2024
This contest prompts applicants to submit a plausible AI threat, exploring interdependent and cascading impacts from the threat, such as social, economic, political, environmental and technological.
Read Winning Entries
Pathogen Threat Contest
April 1 - July 30, 2023
This contest prompted applicants to submit a plausible pathogen emergence story and interdependent social, economic, political, environmental or technological forces that shape the unfolding threat.
Read Winning Entries
Infrastructure Threat Contest
August 1 - October 15, 2023
This contest prompts applicants to submit an original essay describing a threat scenario related to one or more of the 16 critical infrastructure sectors. Complex threat scenarios which include threats across multiple infrastructure sectors are encouraged. Scenarios must be plausible and may explore interdependent social, economic, political, environmental or technological forces that shape the unfolding threat.
Read Winning Entries
Natural Disaster Threat Contest
December 1 - January 31
Participants submitted essays describing a plausible natural disaster threat, exploring interdependent and cascading impacts across systems.
Read Winning Entries